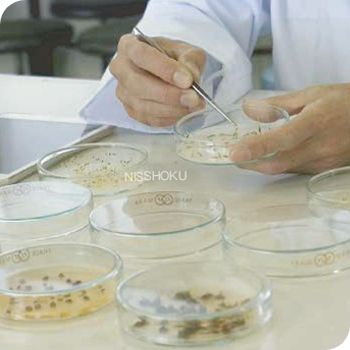

[综合研究圃场]是我们的综合实验基地。它位于日本冈山县美咲町,占地面积约有10公顷,从投入使用到现在已有20多年的历史。日本植生的绿化产品都是在这片试验田里进行反复的测试,达标后才会投放市场。除此之外,我们每年还会请多位客户来现场参观,他们也是我们迈向最终目标——“创造绿色之国”的见证者。




细粒的土壤容易因降雨或侵蚀导致流失,不利于植物的生长。可降解生态布在施工完后会随着夜里的露水或降雨慢慢从网上脱离,在种子发芽前吸附到土壤中。它可以代替根须,在防止细粒土壤,种子,肥料的流失上有显著的效果。可以说是起到了“初期的根须”的功能。
我们的产品,首先从优良的种子着手。严格筛选构成每个产品的素材,从开始制造到完成,品质管理上不做任何妥协,牢牢实实把关。我们确信品质才是“创造绿色之国”的第一步。

我们紧握着时代的需求,不断创造出了足以引领绿化产业的产品,历年积累的经验技术化作参加创造的每一个成员的热忱,也引领我们的产品走向未来。
苏州日植环境技术有限公司
网址:www.sznisshoku.com